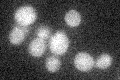
YLR115W
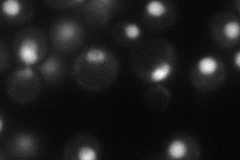
YLR115W
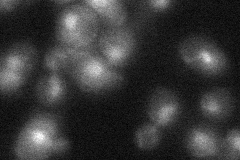
YLR115W

View description
Subunit of the mRNA cleavage and polyadenlylation factor (CPF); required for pre-mRNA cleavage, polyadenylation and poly(A) site recognition, 43% similarity with the mammalian CPSF-100 protein.
Localization:
Intensity:
Fold change:
Significance:
-
C’ GFP library in SD
below threshold16.95 -
N' NOP1pr-GFP in SD
nucleus47.172 -
N' TEF2pr-mCherry in SD

nucleusN/A -
N' NATIVEpr-GFP in SD
nucleus20.9964 -
N' TEF2pr-VC and Cyto-VN in SD

nucleus25.9443 -
C’ GFP library in SD+DTT

cytosol18.911.11No -
C’ GFP library in SD+H2O2

cytosol17.321.02No -
C’ GFP library in Starvation Media

cytosol14.850.87No -
C’ GFP library on the background of Pup2-DaMP

below threshold -
C’ GFP library on the background of CCT mutant

below threshold17.06951.00667No
